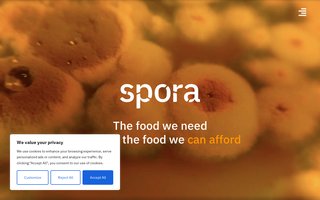

|
bay-larsen.dk
|
Kresten Bay
|
Luftmarinegade 108
|
2026-01-22 |
ok
|
|
—
|
the-firm.dk
|
The Bank Management ApS
|
Refshalevej 159A
|
2026-01-22 |
err
|
|
—
|
devcloud.dk
|
Dental Media ApS
|
Refshalevej 213A
|
2026-01-22 |
err
|

|
dinflexiblesundhed.dk
|
Din Flexible Sundhed
|
Margretheholmsvej 70, 5. tv.
|
2026-01-22 |
ok
|

|
halvandet.dk
|
Copenhagen City Beach Club ApS
|
Refshalevej 325
|
2026-01-22 |
ok
|
|
—
|
allanthuesen.dk
|
Allan Thuesen
|
Margretheholmsvej 60, 3. th
|
2026-01-22 |
err
|

|
spejdernepaaholmen.dk
|
Jørn Schou Sandager
|
Luftmarinegade 2
|
2026-01-22 |
ok
|

|
klubwerkstatt.dk
|
Street Food District ApS
|
Refshalevej 167A, 1.
|
2026-01-22 |
ok
|

|
freetap.dk
|
Kim Skov Lehner
|
Margretheholmsvej 74, 1. tv
|
2026-01-22 |
ok
|

|
hammerknuden.dk
|
Finn Bonnevie Jørgensen
|
Margretheholmsvej 66, 5. th
|
2026-01-22 |
ok
|

|
galilei.dk
|
Jesper Odde Madsen
|
Margretheholmsvej 28, 4. tv
|
2026-01-22 |
ok
|

|
biofoss.dk
|
BIOFOS A/S
|
Refshalevej 250
|
2026-01-22 |
ok
|

|
altomtaender.dk
|
Dental Media ApS
|
Refshalevej 213A
|
2026-01-22 |
ok
|

|
refshaleoen.dk
|
REFSHALEØENS EJENDOMSSELSKAB A/S
|
Refshalevej 153, 2.
|
2026-01-22 |
ok
|
|
—
|
ringedagblad.dk
|
Carsten Schmidt
|
Refshalevej 169F
|
2026-01-22 |
err
|

|
hans.dk
|
SMTP.DK ApS
|
Refshalevej 163A, 1. tv.
|
2026-01-22 |
ok
|

|
aktivaldring.dk
|
BIG MEDIA ApS
|
Refshalevej 163
|
2026-01-22 |
ok
|

|
escape-cph.dk
|
NETWORK AND INNOVATION COMPANY ApS
|
Refshalevej 163D, 1.
|
2026-01-22 |
ok
|

|
annelihoyer.dk
|
Anneli Søgård-Høyer
|
Refshalevej 161N, 1. tv
|
2026-01-22 |
ok
|

|
hztone.dk
|
HZ&TONE ApS
|
William Wains Gade 11
|
2026-01-22 |
ok
|

|
tripledesign.dk
|
Fuzzy House ApS
|
Refshalevej 110A
|
2026-01-22 |
ok
|
|
—
|
rusgilde-festival.dk
|
Sebbe Bo Selvig
|
Luftmarinegade 14
|
2026-01-22 |
err
|

|
vildmad.dk
|
NOMA AF 2003 ApS
|
Refshalevej 213A
|
2026-01-22 |
ok
|

|
biofis.dk
|
BIOFOS A/S
|
Refshalevej 250
|
2026-01-22 |
ok
|

|
blivskiinstruktor.dk
|
SNOWMINDS ApS
|
Refshalevej 151
|
2026-01-22 |
ok
|

|
werkstatt167.dk
|
Street Food District ApS
|
Refshalevej 167A, 1.
|
2026-01-22 |
ok
|

|
kloakservicekbh.dk
|
Kloakservicekbh ApS
|
Refshalevej 163A
|
2026-01-22 |
ok
|

|
dentalmedia.dk
|
Dental Media ApS
|
Refshalevej 213A
|
2026-01-22 |
ok
|

|
alchemist.dk
|
Alchemist ApS
|
Refshalevej 173C
|
2026-01-22 |
ok
|

|
broensstreetfood.dk
|
Street Food District ApS
|
Refshalevej 167A, 1.
|
2026-01-22 |
ok
|

|
kornbeckbonde.dk
|
Jesper Bonde
|
Refshalevej 110A
|
2026-01-22 |
ok
|

|
heatclub.dk
|
Butchers Heat ApS
|
Luftmarinegade 144
|
2026-01-22 |
ok
|

|
aeroedagblad.dk
|
Carsten Schmidt
|
Refshalevej 169F
|
2026-01-22 |
ok
|
|
—
|
svendborgdagblad.dk
|
Carsten Schmidt
|
Refshalevej 169F
|
2026-01-22 |
err
|

|
blacktornado.dk
|
LUNDHOLM ENTERPRISES/ FREEDOM RECORD…
|
Refshalevej 209
|
2026-01-22 |
ok
|

|
musik-dj.dk
|
MusikDJ ApS
|
Refshalevej 163A, 1. th.
|
2026-01-22 |
ok
|

|
streetfooddistrict.dk
|
Street Food District ApS
|
Refshalevej 167A, 1.
|
2026-01-22 |
ok
|

|
ic-concept.dk
|
IChange
|
Refshalevej 163A, 1. th.
|
2026-01-22 |
ok
|

|
sincera.dk
|
SINCERA ApS
|
Refshalevej 147, 3. tv.
|
2026-01-22 |
ok
|

|
mariablaaberg.dk
|
Maria Blaaberg
|
Flyhangargade 8
|
2026-01-22 |
ok
|

|
byenforborgerne.dk
|
Sebbe Bo Selvig
|
Luftmarinegade 14
|
2026-01-22 |
ok
|

|
b-arki.dk
|
FONDEN TIL UDGIVELSE AF ARKITEKTURTI…
|
William Wains Gade 9
|
2026-01-22 |
ok
|

|
jesbrinch.dk
|
Jes Tomas Brinch
|
Margretheholmsvej 40, 4. th
|
2026-01-22 |
ok
|

|
gadegrej.dk
|
Gadeforeningen
|
Refshalevej 165B
|
2026-01-21 |
ok
|

|
bonfilsconsulting.dk
|
Bonfils Consulting/Therese Trading
|
Refshalevej 163A, 1. th.
|
2026-01-21 |
ok
|

|
werkstatt-venue.dk
|
Street Food District ApS
|
Refshalevej 167A, 1.
|
2026-01-21 |
ok
|

|
bondebrothers.dk
|
Jesper Bonde
|
Refshalevej 110A
|
2026-01-21 |
ok
|

|
wplus.dk
|
J. WALDORFF HOLDING ApS
|
Luftmarinegade 58
|
2026-01-21 |
ok
|

|
sortplushvid.dk
|
Enel Laura Pagaard Selvig
|
Luftmarinegade 14
|
2026-01-21 |
ok
|

|
outbackoriginals.dk
|
EMLIKA ApS
|
Refshalevej 145F
|
2026-01-21 |
ok
|

|
lindahl-thyssen.dk
|
Kell Noring Thyssen
|
Luftmarinegade 148
|
2026-01-21 |
ok
|

|
butchersheat.dk
|
Butchers Heat ApS
|
Luftmarinegade 144
|
2026-01-21 |
ok
|

|
taramps.dk
|
SOUNDBIKE
|
Refshalevej 194
|
2026-01-21 |
ok
|

|
glampingdenmark.dk
|
Anette Maria Syska
|
Refshalevej 141B
|
2026-01-21 |
ok
|

|
dengraahal.dk
|
Direktionen - Den Grå Hal
|
Refshalevej 2
|
2026-01-21 |
ok
|

|
jespermadsen.dk
|
Jesper Odde Madsen
|
Margretheholmsvej 28, 4. tv
|
2026-01-21 |
ok
|

|
byensejendom.dk
|
Carsten Schmidt
|
Refshalevej 169F
|
2026-01-21 |
ok
|

|
minimorfi.dk
|
Fuzzy House ApS
|
Refshalevej 110A
|
2026-01-21 |
ok
|

|
psykoterapikbh.dk
|
Psykoterapi København
|
Luftmarinegade 116
|
2026-01-21 |
ok
|

|
theartist.dk
|
The Artist ApS
|
Refshalevej 159A
|
2026-01-21 |
ok
|

|
gymmus.dk
|
GYMNASIESKOLERNES MUSIKLÆRERFORENING
|
Margretheholmsvej 39
|
2026-01-21 |
ok
|

|
calmacph.dk
|
Martin Tradsborg Christophersen
|
Luftmarinegade 4
|
2026-01-21 |
ok
|

|
lenehansson.dk
|
Lenemai Jazmin Katarina Christensen
|
Margretheholmsvej 20, 7. tv
|
2026-01-21 |
ok
|

|
choic.dk
|
IChange
|
Refshalevej 163A, 1. th.
|
2026-01-21 |
ok
|

|
nl-landskab.dk
|
Jesper Bonde
|
Refshalevej 110A
|
2026-01-21 |
ok
|

|
reeftv.dk
|
True Story Holding ApS
|
William Wains Gade 11
|
2026-01-21 |
ok
|

|
nybodersnaps.dk
|
Ryberg Enterprises
|
Margretheholmsvej 48, 6. th.
|
2026-01-21 |
ok
|

|
snedkeriet-flex.dk
|
Flex Montering & Snedkeri
|
Margretheholmsvej 70, 3. th.
|
2026-01-21 |
ok
|

|
thomaskofod.dk
|
Thomas Kofod
|
Luftmarinegade 112
|
2026-01-21 |
ok
|

|
sygeplejerskehuset.dk
|
Pernille Rønde Østergaard
|
Margretheholmsvej 40, 6. tv
|
2026-01-21 |
ok
|

|
mistanke.dk
|
Steinunn Herdis Gudbrandsdottir
|
Luftmarinegade 62
|
2026-01-21 |
ok
|

|
laurafriberg.dk
|
Laura Friberg Nielsen
|
Margretheholmsvej 56, 5. th
|
2026-01-21 |
ok
|

|
nycirkuspaaskemaet.dk
|
KØBENHAVNS INTERNATIONALE TEATER
|
Refshalevej 163A, 1.
|
2026-01-21 |
ok
|

|
madmagi.dk
|
Alchemist ApS
|
Refshalevej 173C
|
2026-01-21 |
ok
|

|
flexmontering.dk
|
Snedkeriet Flex
|
Margretheholmsvej 70, 3. th.
|
2026-01-21 |
ok
|

|
havnerundfart.dk
|
NETTO-BÅDENE A/S
|
Refshalevej 350
|
2026-01-20 |
ok
|

|
luftmarinegade.dk
|
Steinunn Herdis Gudbrandsdottir
|
Luftmarinegade 62
|
2026-01-20 |
ok
|

|
okamicph.dk
|
Christian Wolf Windum
|
Margretheholmsvej 46, 5. tv
|
2026-01-20 |
ok
|

|
kloaklab.dk
|
BIOFOS A/S
|
Refshalevej 250
|
2026-01-20 |
ok
|

|
ribalex.dk
|
CPH Shipping ApS
|
Refshalevej 340
|
2026-01-20 |
ok
|

|
barlbycarlsson.dk
|
BARLBY + CARLSSON ApS
|
Refshalevej 171C
|
2026-01-20 |
ok
|

|
skischoolcopenhill.dk
|
SNOWMINDS ApS
|
Refshalevej 151
|
2026-01-20 |
ok
|

|
digitalkreativitet.dk
|
Martin Thun Klausen
|
Margretheholmsvej 68, 5. tv
|
2026-01-20 |
ok
|
|
—
|
faaborgdagblad.dk
|
Carsten Schmidt
|
Refshalevej 169F
|
2026-01-20 |
err
|

|
elitenetwork.dk
|
NETWORK AND INNOVATION COMPANY ApS
|
Refshalevej 163D, 1.
|
2026-01-20 |
ok
|

|
metropolis.dk
|
KØBENHAVNS INTERNATIONALE TEATER
|
Refshalevej 163A, 1.
|
2026-01-20 |
ok
|

|
ai.dk
|
AI A/S
|
Refshalevej 147, 2.
|
2026-01-20 |
ok
|

|
cafefusion.dk
|
Sophia Teresa Bien Huynh
|
Margretheholmsvej 4, 2. tv
|
2026-01-20 |
ok
|
|
—
|
paintballarena.dk
|
COPENHAGEN PAINTBALL ARENA ApS
|
Refshalevej 177A
|
2026-01-19 |
err
|

|
nllandscape.dk
|
Jesper Bonde
|
Refshalevej 110A
|
2026-01-19 |
ok
|
|
spora.dk
|
Spora ApS
|
Refshalevej 153, st.
|
2026-01-19 |
ok
|

|
lydeking-olesen.dk
|
Mette Lydeking Olesen
|
Margretheholmsvej 58, 3. tv
|
2026-01-19 |
ok
|

|
bygnica.dk
|
Bjarke Krüger Molin
|
Margretheholmsvej 72, 4. tv
|
2026-01-19 |
ok
|

|
aamanns.dk
|
Aamanns ApS
|
Refshalevej 163A
|
2026-01-19 |
ok
|

|
stormspakhus.dk
|
Street Food District ApS
|
Refshalevej 167A, 1.
|
2026-01-18 |
ok
|

|
lighthousecph.dk
|
Lighthouse Copenhagen
|
Refshalvej 209A
|
2026-01-18 |
ok
|
|
—
|
100pctfremmed.dk
|
100% København
|
Refshalevej 163A, 1.
|
2026-01-17 |
err
|